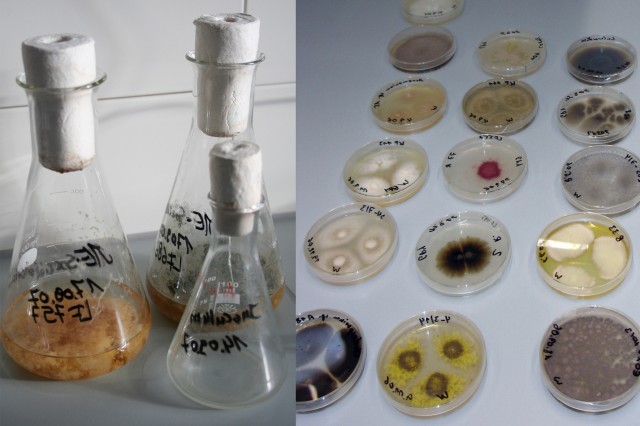

Medikamente aus dem Meer
Die Medizin, die aus der Tiefe kommt
Kieler Forscher untersuchen maritimes Leben auf medizinische Wirkstoffe.
365 Orte 2009
GEOMAR - Helmholtz-Zentrum für Ozeanforschung Kiel
Wischhofstr. 1-3
24106 Kiel
Schleswig-Holstein